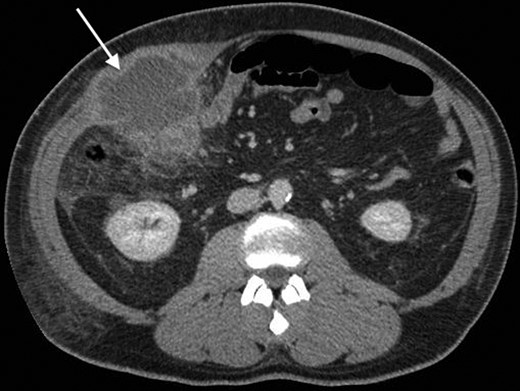
An axial CT with contrast showing the RUQ appendiceal abscess.

-
PDF
- Split View
-
Views
-
Cite
Cite
Gary Sharp, Nicholas Railton, Sritharan Kadirkamanathan, A mystifying mass, Journal of Surgical Case Reports, Volume 2014, Issue 1, January 2014, rjt123, https://doi.org/10.1093/jscr/rjt123
Close - Share Icon Share
Abstract
A 57-year-old male was referred by his general practitioner (GP) to hospital with right upper quadrant pain and a palpable mass (10 × 9 cm). He had been assessed by his GP several weeks earlier and represented as initial treatment failed. On his second presentation a mass was evident and thought to represent cholecystitis by the referring GP. However, the correct and prompt use of appropriate radiological imaging enabled swift diagnosis and management of atypical acute appendicitis through microbial specific therapy. Atypical appendicitis delays diagnosis and treatment which represents greater levels of appendiceal ischaemia and heightened perforation risk. This case study highlights the non-surgical management of acute atypical appendicitis and also reinforces the use of appropriate imaging modalities.
INTRODUCTION
Acute appendicitis is defined as inflammation of the vermiform appendix [1] and is a possible differential diagnosis in the large majority of patients who present to the emergency department with acute abdominal pain. Appendicitis is more common in males and around 70% of acute appendicitis presentations occur in those aged <30 years [1]. The typical clinical history of central abdominal pain migrating to the right iliac fossa is not always present and atypical presentations can be difficult to diagnose clinically. Atypical presentations in older aged patients can lead to diagnostic difficulties culminating in greater complications and morbidity [2] coupled with a greater perforation risk [1]. Atypical presentations are poorly reported in the literature and this case highlights appropriate investigation and management of one such case.
CASE HISTORY
A 57-year-old male presented to the emergency department complaining of acute ‘sharp/stabbing’ right upper quadrant (RUQ) pain, intentional weight loss (19 kg) and night sweats. His general practitioner (GP) had prescribed antibiotics and analgesia on his initial presentation. Continued abdominal pain prompted the patient to return to his GP upon which an abdominal mass was identified and a presumptive diagnosis of cholecystitis made. He was referred to the local emergency department and reviewed by the surgical team.
His past surgical history included conservatively managed renal calculi and left inguinoscrotal herniorrhaphy. Right hypochondrial palpation identifying a tender, well-defined, hard, smooth edged, non-pulsatile, non-fluctuant mass (10 × 9 cm). Observations were within normal limits and systemic examinations unremarkable. Haematological results showed the following: albumin 27, WCC 15.7, neutrophils 11.0, CRP 341, amylase 20. Urinalysis, chest and abdominal radiographs (AXR) were normal. Initial resuscitative management was commenced and a contrast enhanced computed tomography (CT) performed. This demonstrated an anterior abdominal wall collection (7 cm) arising from an RUQ appendiceal abscess secondary to acute appendicitis (Figs 1 and 2). Consequent ultrasound (US) guided drainage and pigtail catheter insertion removed 50 ml of frank pus, which isolated pathogens sensitive to penicillin and erythromycin. Following 3 days of intravenous piperacillin and tazobactam (Tazocin®) he was discharged with oral erythromycin. An out-patient barium follow-through and colonoscopy were unremarkable.
An axial CT with contrast showing the RUQ appendiceal abscess.

A coronal CT with contrast showing the tail of the appendix communicating with the appendiceal abscess.
DISCUSSION
Appendicitis is the world's most common surgical emergency [3, 4]. Lifetime risk of appendicitis is between 6 and 8% [5] with various appendiceal orientations described [1]. The appendix can originate anywhere within a 360° circumference of the caecum [6] resulting in a variety of atypical presentations if inflamed [2].
The question still remains how the appendix managed to migrate to the RUQ? The answer lies in foetal development of the primitive gut from Weeks 4 to 10. The primitive gut protrudes through the anterior abdominal wall, rotates 270° counter clockwise and then re-enters the abdominal cavity. The jejunum re-enters first, ileum next and caecum last to initially reside in the RUQ, from here the caecum migrates inferiorly to its final destination within the right iliac fossa (RIF) [7]. In this patient the inferior progression of the caecum failed hence the atypical presentation.
The ‘typical’ presentation of appendicitis, classified as periumbilical pain that migrates to the RIF, occurs in only 50% of patients [4]. Atypical presentations remain diagnostic conundrums which lead to greater morbidity [2] and greater perforation risk [2, 3, 5, 6]. The above atypical presentation hampered diagnosis as it lacked the usual features of appendicitis, plus the patient’s age made appendicitis less likely [1, 3].
AXR is unnecessary when diagnosing appendicitis, although a calcified faecolith might be visible [4]. Nevertheless, it is an essential tool to rule out other abdominal pathology [1]. US is the ideal modality to investigate and potentially drain such a mass. It requires no prior preparation from patients or clinical staff, is inexpensive and quick [4] leading to prompt resolution, together with specimen collection to aid therapy. The main shortcoming of US relates to operator dependence and pain due to probe pressure over underlying pathology [4, 5].
CT usually complements US when diagnosing acute appendicitis [4] but due to the patient's atypical presentation it was justified as the initially investigation. The sensitivity of CT is superior to that of US in diagnosing acute appendicitis [5] and is an excellent adjunct in atypical presentations [1, 4]. Risks associated with CT are ionized radiation and contrast nephrotoxicity [1, 5]. The mass visualized on CT occurred due to the omentum and surrounding structures ‘walling-off’ the inflammatory process associated with acute perforated appendicitis [1]. Patients with such concealed collections are more favourably treated conservatively and have a lower recurrence rate [1]. Percutaneous drainage and intravenous antibiotics appear to be the management of choice to avoid the greater level of morbidity linked with immediate appendicectomy [5]. The correct use of various imaging modalities led to prompt organism-specific antimicrobial therapy and negated the need for surgery and its associated morbidity.
Several authors suggest conservatively treated appendicitis results in less morbidity and a shorter duration of hospitalization when compared with those managed with an acute appendicectomy [8]. However, antimicrobial treatment alone should only be contemplated in the non-peritonitic patient [1]. The major drawback of antibiotic management is recurrence, with some authors reporting a 15% recurrence rate in the year following anti-microbial treatment only [1]. Nevertheless, medical management avoids common post-operative complications such as wound infection, dehiscence and pelvic/abdominal collections [1, 5]. Moreover, 3% of patients 10 years post-appendicectomy present with bowel obstruction secondary to adhesions [9]. Even so, in a recent randomized controlled trial which looked at co-amoxiclav treatment versus acute appendicectomy in uncomplicated appendicitis findings suggest antibiotic treatment alone was inferior to appendicectomy [9]. There is no conclusive data to recommend the preferential use of non-operative management of appendicitis, rather it should be considered [5].
The fact that this patient had already consulted his GP and was misdiagnosed mirrors findings by other authors who suggest that only half of patients aged over 50 are diagnosed correctly with acute appendicitis on their first presentation [10]. Appendicitis presentation is not always typical and the atypical presentation leads to greater morbidity. This case highlights atypical appendicitis presentations and the correct use of radiological imaging whilst minimizing the need for surgical intervention and its associated morbidity.